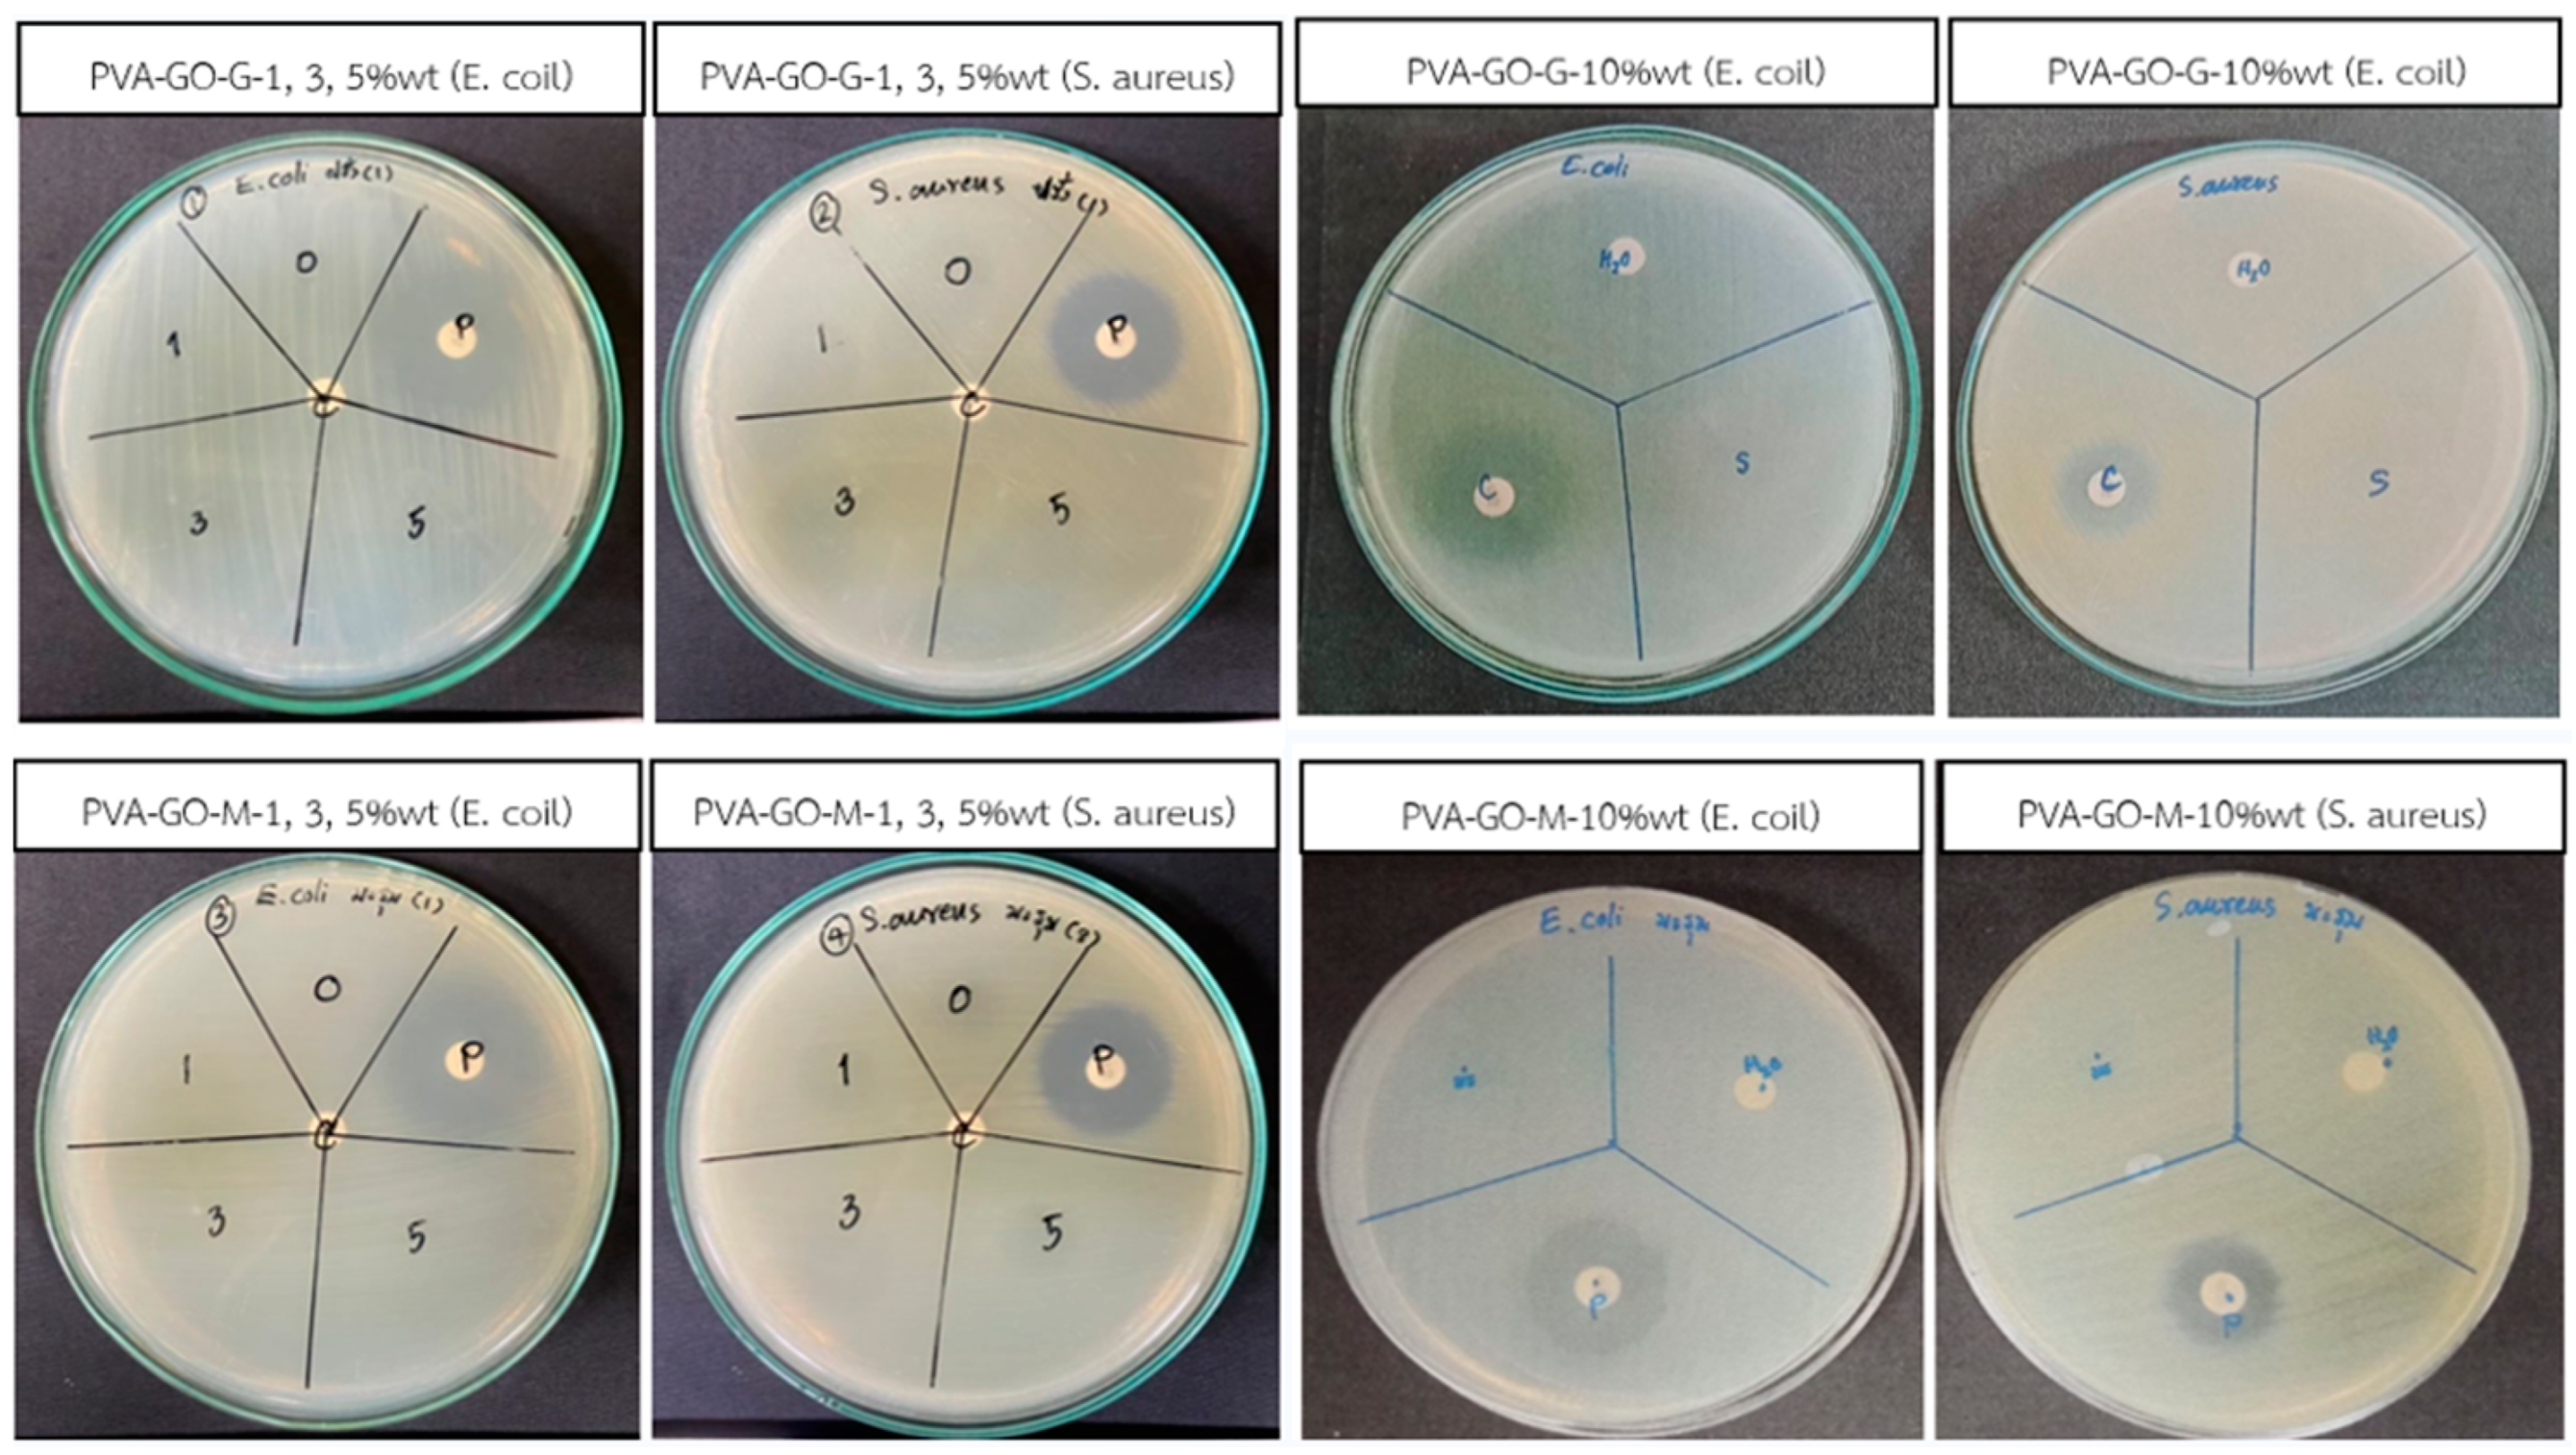
Engproc 56 00144 g002

Abstract
Antibacterial agents produced from plant extracts are seen as a promising application in food packaging. Essential oil extracts, on the other hand, often have drawbacks such as long-term instability, limited bioavailability, and fast burst release. This study’s primary goal was to develop poly(vinyl alcohol) (PVA)/graphene oxide (GO) nanocomposite films for use in food packaging, utilizing moringa (M) and guava (G) leaf extracts. The characteristics of polymer films were enhanced by adding a small quantity of GO as a reinforcing filler, and then adding phenolic and flavonoid compounds as antibacterial agents. First, GO and plant extracts were dispersed through the use of ultrasonication. Next, all chemicals were introduced in the PVA matrix with the use of a straightforward and eco-friendly solution casting approach. Water was used as the solvent for this process. As a consequence of these findings, PVA/GO/M3% films demonstrated superior tensile strength (73.63 MPa), % elongation at break (641.94%), and modulus (23.84 MPa) in comparison to neat PVA films. The GO was an effective reinforcing filler, while phenolic and flavonoid compounds were, respectively, crystallization agents. They were distributed randomly in the PVA matrix with no preferred orientation and some agglomeration. Furthermore, the antibacterial activity of the synthetic films loaded with M and G leaf extracts was low when tested against Escherichia coli (E. coli) and Staphylococcus aureus (S. aureus).
1. Introduction
Polymer nanocomposites have significant use in a variety of industries, including the automotive and aerospace industries, the food packaging application, and even the medical area. In addition to being the polymeric material that can be worked with most easily, it also boasts a high strength to weight ratio. As a host for many different kinds of nanofillers, water-soluble polymers such as poly(vinyl alcohol), also known as PVA, are almost usually utilized [1]. PVA has a high degree of transparency, is hydrophilic, and has adhesive qualities, making it a widely used commercial polymer. It is also used in the production of fibers, food packaging, and biomedicine due to its strong oxygen barrier properties and its mechanical and biodegradable characteristics. Clay, carbon nanotubes, graphene and its derivatives, metal oxide nanoparticles, and other inorganic nanomaterials have all been incorporated into a PVA matrix to enhance the mechanical, electrical, and surface dewetting properties [2].
In recent years, graphene has gained popularity as a material of interest due to the exceptional electrical, optical, thermal, and mechanical functions it possesses. Graphene is a two-dimensional sheet of a sp2-hybridized carbon structure. Because of this, it is an excellent contender for a wide variety of applications, including nanoelectronics, nanocomposites, nanomedicine, chemical and biological sensors, supercapacitors, membranes for gas separation, and hydrogen storage [3,4].
Graphene oxide, abbreviated as GO, is an essential step in the production of graphene, a material that has a great deal of oxygen- and hydrogen-containing hydrophilic functional groups. Due to the fact that the carbon skeleton structure of GO is comparable to that of graphene, its mechanical properties are similarly exceptional. It was believed that employing GO as a mechanical reinforcement could be an effective way to manufacture high-performance composite materials, which would result in high strength, high modulus, low thickness, and light weight [5].
Microorganisms are abundant in the environment and can easily contaminate food at any point in the production chain, including harvesting, slaughtering, processing, and packing. There must be a shift toward non-chemical alternatives to preservatives in order to slow the spread of disease-causing germs and increase the storage life of perishable foods. Many scientists have been looking into whether or not certain plant extracts may be used as reliable natural preservatives, and their findings have been promising [6].
In the present study, the researchers developed PVA nanocomposites integrated with a blend of essential oil extracts and GO, with the aim of utilizing them in food packaging applications. The leaves of the moringa (M) and guava (G) plants were chosen for extraction. The objective of this study was to investigate the compatibility between polymers and fillers in order to facilitate the development of films. Subsequently, the nanocomposite films were characterized in terms of their mechanical and antibacterial properties.
2. Experimental Procedure
PVA pellet (JP-18Y, Japan Vam & Poval Co., Ltd., Osaka, Japan) was utilized as a polymer matrix for this project. UGENT TECH SDN BHD (Malaysia) was the source of the aqueous-based GO that was purchased. The fresh M and G leaves were taken from trees that had been established at agriculture farms in the western region of Thailand. The extracts collected from the M and G leaves were forwarded to the Kasetsart Agricultural and Agro-Industrial Product Improvement Institute in Thailand for testing and evaluating the quantity and quality. Analytical grade reagents were utilized for all other compounds.
After being washed with distilled water, the M and G leaves were then chopped up into smaller pieces. Following that, 95% ethanol was added for extraction of essential oils using a mass ratio of plants to solvent of 1 g per 5 mL, and the mixture was shaken on a shaker at a speed of 200 rpm for 24 h. In the end, they were filtered using filter paper number 1 [7].
In the beginning, 10 g of PVA powder was mixed with 100 mL of distilled water and 20 wt.% of glycerol before being heated in an Erlenmeyer flask to a temperature of 90 °C for 3 h. This was done so that the ingredients could be dissolved together. PVA solution was then combined with a GO solution that included 1 wt.% of PVA and was heated to 90 °C. It was then sonicated at a high frequency for 1 h while being stirred. The essential oil extracts were obtained; the amount of each leaf extract was 0, 1, 3, 5, and 10 wt.% of GO, respectively. It was combined with the solution that was created earlier at a temperature of 90 °C until it was dissolved, and then it was poured onto an aluminum tray. After that, it was dried at 60 °C for 24 h in an oven.
The investigation into the mechanical properties of polymer nanocomposites by applying a tensile test was carried out on a universal testing machine in accordance with the testing standard ASTM-D882. After cutting the sample film into a rectangular sheet measuring 6 inches by 1 inch, the standard deviation of the film’s thickness was determined. For mechanical testing, a load cell capable of measuring 5 kN with a pull speed of 50 mm/min. The elongation at break, as well as the tensile strength and Young’s modulus of plant extract-loaded PVA/GO nanocomposites films were measured. At least 5 separate trials of the experiment were conducted, and the results were averaged.
In addition, the potential of food packaging to inhibit the growth of Escherichia coli (E. coli) and Staphylococcus aureus (S. aureus) was investigated by an experiment utilizing the disk diffusion method, which is described in the review of the relevant literature [8,9]. For this evaluation, the diameter of the growth inhibition zones was measured in millimeters to determine their effectiveness. The measurements of the inhibitory zones were carried out for each test a total of three times [10].
3. Results and Discussion
The values of M and G plant extracts’ total phenolic content (TPC), total flavonoid content (TFC), and inhibitory concentration (IC)-50 are presented in Table 1. The amount of TPC and TFC found in the G leaf extract is significantly higher than that found in the M leaf extract. The TPC and TFC of the G extract both averaged out to be 2.230 mg gallic acid/g sample and 1.131 mg catechin/g sample, respectively. The amount of an antioxidant-containing compound needed to scavenge 50% of the initial 2,2-diphenyl-1-picrylhydrazyl (DPPH) radical scavenging is known as the IC-50 value. Higher antioxidant activity is implied by a substance’s ability to scavenge DPPH with a lower IC-50 value [11,12]. The IC-50 value of the M leaves is 26,746 µg/mL, followed by the IC-50 value of the G leaves, which is 2240 µg/mL on average. When compared to other study investigations, it was shown that the essential oil extracts collected from different trees in each region are distinct from one another. This could be a result of the topography, which affects the pH of the soil and the amount of water. The amount of material that is contained inside the leaves is also affected by environmental factors such as temperature and sunlight. The amount of water that is contained within the leaves might vary depending on the environment, due to the fact that different plants have unique extracts [13].
Table 1.
TPC, TFC, and IC-50 values of M and G plant extracts.
Figure 1 displays the mechanical properties of PVA mixed with GO and plant leaf extracts at 0, 1, 3, 5, and 10 wt.% using a universal testing machine. The elongation at the break of PVA/GO film blends containing both M and G extracts was decreased, but the tensile strength and Young’s modulus were increased. Due to their capacity to act as reinforcing fillers, the GO found in the polymer matrix is the reason for this. An increase in the elongation at break, tensile strength, and Young’s modulus were observed when the amount of plant extract added to them reached a concentration of 3 wt.%. As a result, the structure’s strength and percentage of crystallinity increased, increasing both mechanical and overall strength. The addition of M and G leaf extracts at 5 and 10 weight percent led to a decrease in both the tensile strength and Young’s modulus of the material. It was discovered that there was a decline in the proportion of crystallinity. According to the findings of the study, increasing the concentration of either of the plant extracts containing the ingredient TPC resulted in nearly the same elongation of the material before it broke. There is a possibility that the phenolic chemicals’ benzene ring structure contributes to the material’s increased strength [14].
Figure 1.
Tensile strength, Young’s modulus, and elongation at break of PVA/GO mixed with M and G leaf extracts at 0, 1, 3, 5, and 10 wt.%.
Furthermore, PVA/GO/M3% films showed a better tensile strength of 73.63 MPa, Young’s modulus of 23.84 MPa, and elongation at break of 641.94% in comparison to neat PVA films as a result of these findings. Because the GO served as an efficient reinforcing filler, phenolic and flavonoid chemicals in M and G plant extracts were utilized in their respective roles as crystallization agents. They were dispersed at random throughout the PVA matrix, with no particular orientation being favored and some clumping occurring.
The disc diffusion assay is a method that is used to evaluate the effectiveness of the M and G extracts on a particular species, specifically E. coli and S. aureus. Figure 2 presents the findings that were obtained from the disc diffusion assay. When tested against E. coli and S. aureus, the antibacterial activity of synthetic films loaded with M and G leaf extracts was shown to be quite low. PVA/GO has a considerable tendency toward aggregation because of the presence of strong van der Waals contacts between the nanosheets [2], which can be attributed to the considerably decreased antibacterial activity of PVA/GO when compared to the antibacterial activity of PVA/GO that was treated with leaf extract [15].
Figure 2.
The images of disc diffusion assay on E. coli and S. aureus by PVA/GO mixed with M and G leaf extracts at 0, 1, 3, 5, and 10 wt.%.
4. Conclusions
In this investigation, mixing PVA film with GO and plant extracts resulted in improvements to the mechanical and antibacterial properties of the film. Specifically, in packaging films loaded with M 3 wt%, the produced films displayed significant tensile strength, Young’s modulus, and elongation at break. In addition, these findings point to the possibility that an antibacterial film can be made out of a PVA/GO film that contains M and G plant extracts. Further investigation is required to determine the biocompatibility of films, as well as their releasing and loading abilities.
Author Contributions
All of the authors participated in a collaborative endeavor to produce this work. A.B. was responsible for the design of the experiments, the analysis of the data, and the initial drafting of the manuscript, which was then extensively revised. P.P., P.N., and A.N. were responsible for the laboratory experiments. V.L. contributed to the conceptual approach and discussion of the results, and he approved the final version of the revised manuscript. All authors have read and agreed to the published version of the manuscript.
Funding
This research received no external funding.
Institutional Review Board Statement
Not applicable.
Informed Consent Statement
Not applicable.
Data Availability Statement
Data are contained within the article.
Acknowledgments
The authors would also like to thank the Department of Materials Science and Engineering, Faculty of Engineering and Industrial Technology at Silpakorn University for their support and assistance with this project.
Conflicts of Interest
The authors declare no conflict of interest.
References
- Abdullah, A.H.; Ismail, Z.; Abidin, A.S.Z.; Ismail, F.S.; Yusoh, K. PVA/graphene nanocomposite: Morphology and its thermal properties. IOP Conf. Ser. Mater. Sci. Eng. 2018, 319, 012011. [Google Scholar] [CrossRef]
- Cho, B.-G.; Joshi, S.R.; Lee, S.; Kim, S.-K.; Park, Y.-B.; Kim, G.-H. Enhanced mechanical and antibacterial properties of nanocomposites based on poly(vinyl alcohol) and biopolymer-derived reduced graphene oxide. Polymers 2021, 13, 615. [Google Scholar] [CrossRef] [PubMed]
- Buasri, A.; Ananganjanakit, T.; Peangkom, N.; Khantasema, P.; Pleeram, K.; Lakaeo, A.; Arthnukarn, J.; Loryuenyong, V. A facile route for the synthesis of reduced graphene oxide (RGO) by DVD laser scribing and its applications in the environment-friendly electrochromic devices (ECD). J. Optoelectron. Adv. Mater. 2017, 19, 492–500. [Google Scholar]
- Buasri, A.; Ojchariyakul, S.; Kaewmanechai, P.; Eakviriyapichat, W.; Loryuenyong, V. The fabrication of multicolor electrochromic device based on graphene conductive ink/poly(lactic acid) thin films by voltage-step method. Optoelectron. Adv. Mater. Rapid Commun. 2018, 12, 388–393. [Google Scholar]
- Cheng-an, T.; Hao, Z.; Fang, W.; Hui, Z.; Xiaorong, Z.; Jianfang, W. Mechanical properties of graphene oxide/polyvinyl alcohol composite film. Polym. Polym. Compos. 2017, 25, 11–16. [Google Scholar] [CrossRef]
- Gonelimali, F.D.; Lin, J.; Miao, W.; Xuan, J.; Charles, F.; Chen, M.; Hatab, S.R. Antimicrobial properties and mechanism of action of some plant extracts against food pathogens and spoilage microorganisms. Front. Microbiol. 2018, 9, 1639. [Google Scholar] [CrossRef] [PubMed]
- Soud, S.A.; Hasoon, B.A.; Abdulwahab, A.I.; Hussein, N.N.; Maeh, R.K. Synthesis and characterization of plant extracts loaded PVA/PVP blend films and evaluate their biological. EurAsian J. Biosci. 2020, 14, 2921–2931. [Google Scholar]
- Ngamsurach, P.; Praipipat, P. Antibacterial activities against Staphylococcus aureus and Escherichia coli of extracted Piper betle leaf materials by disc diffusion assay and batch experiments. RSC Adv. 2022, 12, 26435. [Google Scholar] [CrossRef] [PubMed]
- Ordon, M.; Zdanowicz, M.; Nawrotek, P.; Stachurska, X.; Mizielińska, M. Polyethylene films containing plant extracts in the polymer matrix as antibacterial and antiviral materials. Int. J. Mol. Sci. 2021, 22, 13438. [Google Scholar] [CrossRef] [PubMed]
- Buasri, A.; Tanayapong, T.; Cherdkun, N.; Paengjun, N.; Loryuenyong, V. Fabrication and testing of poly(vinyl alcohol)/graphene nanocomposites films for food packaging. In Proceedings of the The 30th TIChE Conference (TIChE2021), Suranaree University of Technology, Nakhon Ratchasima, Thailand, 6–7 May 2021. [Google Scholar]
- Olugbami, J.O.; Gbadegesin, M.A.; Odunola, O.A. In vitro evaluation of the antioxidant potential, phenolic and flavonoid contents of the stem bark ethanol extract of Anogeissus leiocarpus. Afr. J. Med. Med. Sci. 2014, 43, 101–109. [Google Scholar] [PubMed]
- Ghasemzadeh, A.; Azarifar, M.; Soroodi, O.; Jaafar, H.Z.E. Flavonoid compounds and their antioxidant activity in extract of some tropical plants. J. Med. Plants Res. 2012, 6, 2639–2643. [Google Scholar] [CrossRef]
- Zahidah, W.Z.W.N.; Noriham, A.; Zainon, M.N. Antioxidant and antimicrobial activities of pink guava leaves and seeds. J. Trop. Agric. Food Sci. 2013, 41, 53–62. [Google Scholar]
- Yao, J.; Mao, L.; Wang, C.; Liu, X.; Liu, Y. Development of chitosan/poly (vinyl alcohol) active films reinforced with curcumin functionalized layered clay towards food packaging. Prog. Org. Coat. 2023, 182, 107674. [Google Scholar] [CrossRef]
- Bodea, I.M.; Cătunescu, G.M.; Pop, C.R.; Fit, N.I.; David, A.P.; Dudescu, M.C.; Stănilă, A.; Rotar, A.M.; Beteg, F.I. Antimicrobial properties of bacterial cellulose films enriched with bioactive herbal extracts obtained by microwave-assisted extraction. Polymers 2022, 14, 1435. [Google Scholar] [CrossRef] [PubMed]
Disclaimer/Publisher’s Note: The statements, opinions and data contained in all publications are solely those of the individual author(s) and contributor(s) and not of MDPI and/or the editor(s). MDPI and/or the editor(s) disclaim responsibility for any injury to people or property resulting from any ideas, methods, instructions or products referred to in the content. |
© 2023 by the authors. Licensee MDPI, Basel, Switzerland. This article is an open access article distributed under the terms and conditions of the Creative Commons Attribution (CC BY) license (https://creativecommons.org/licenses/by/4.0/).